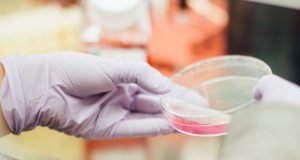

Tim Peneliti Inggris Menguji Coba Vaksin Virus Corona pada Tikus
Sebuah tim yang terdiri dari para ilmuwan dari Inggris dilaporkan telah melakukan uji coba vaksin virus corona baru pada hewan. Seperti yang kita ketahui...
90% Gen Dalam Virus ini Tidak Diketahui dan Dianggap Unik
Para peneliti telah menemukan sejenis virus yang dianggap misterius karena hampir dari seluruh genomnya tidak diketahui dan dianggap baru bagi sains. Virus ini dinamai...
Penyakit Langka Manusia Ditemukan Pada Fosil Dinosaurus
Fosil ekor dinosaurus berusia 60 juta tahun yang ditemukan di Alberta, Kanada, adalah milik dari seekor hadrosaurus. Tidak seperti fosil dinosaurus yang biasa ditemukan,...
Mengapa Virus Kelelawar Begitu Mematikan?
Sebuah penelitian menemukan bahwa respon kekebalan yang luar biasa dari kelelawar terhadap virus di sisi lain dapat menyebabkan virusnya untuk bereplikasi lebih cepat. Ketika...